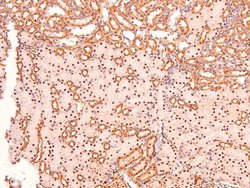
Invitrogen Phospho-Caveolin 2 (Ser36) Polyclonal Antibody 100 &mu;L | Buy Online | Invitrogen&trade; | Fisher Scientific

missing translation for 'onlineSavingsMsg'
Learn More
Learn More
Invitrogen™ Phospho-Caveolin 2 (Ser36) Polyclonal Antibody


Description
Antibody detects endogenous levels of Caveolin 2 only when phosphorylated at Ser36.
Caveolae are specialized domains of the plasma membrane that are implicated in the sequestration of a variety of lipid and protein molecules. It has been suggested that these important cellular organelles have a pivotal role in such diverse biochemical processes as lipid metabolism, growth regulation, signal transduction, and apoptosis. Caveolin interacts with and regulates heterotrimeric G-proteins. Currently, there are three members of the caveolin multigene family which are known to encode 21-24 kDa integral membrane proteins that comprise the major structural component of the caveolar membrane in vivo. Caveolin-2 protein is abundantly expressed in fibroblasts and differentiated adipocytes, smooth and skeletal muscle, and endothelial cells. The expression of caveolin-1 is similar to that of caveolin-2 while caveolin-3 expression appears to be limited to muscle tissue types.

Specifications
Specifications
| Antigen | Phospho-Caveolin 2 (Ser36) |
| Applications | Immunohistochemistry (Paraffin), Western Blot |
| Classification | Polyclonal |
| Concentration | 1 mg/mL |
| Conjugate | Unconjugated |
| Formulation | PBS with 50% glycerol and 0.02% sodium azide; pH 7.4 |
| Gene | CAV2 |
| Gene Accession No. | P51636, Q2IBC5, Q9WVC3 |
| Gene Alias | AI447843; CAV; CAV2; caveolae; caveolae protein, 20-kD; caveolin 2; caveolin 2 isoform a and b; caveolin-2; MGC12294; Phospho-CAV2 |
| Gene Symbols | CAV2 |
| Show More |
Product Title
By clicking Submit, you acknowledge that you may be contacted by Fisher Scientific in regards to the feedback you have provided in this form. We will not share your information for any other purposes. All contact information provided shall also be maintained in accordance with our Privacy Policy.
Spot an opportunity for improvement?